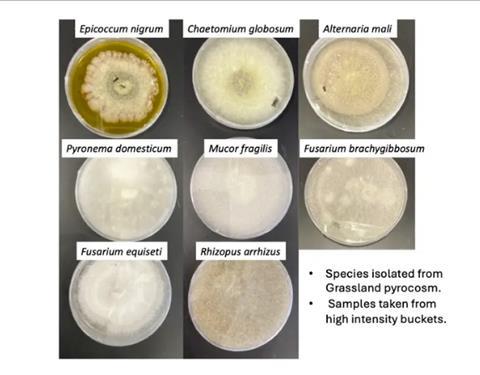
Fungi charcoal 2

Wildfire causes most living things to flee or die, but some fungi thrive afterward, even feasting on charred remains. New University of California, Riverside research finds the secret to post-fire flourishing hidden in their genes.

The study, detailed in the Proceedings of the National Academy of Sciences, is among the first to investigate how fungi that are barely detectable in the soil before a fire are able to proliferate wildly once an area has burned.
“We knew certain fungi were heat resistant, that some could grow quickly in scars where competitors have been burned away, and that others could consume nutrients in charcoal,” said Sydney Glassman, UCR associate professor of microbiology and plant pathology and paper corresponding author. “Now we know the genetics behind these incredible abilities.”
READ MORE: Microbes bingeing on burned soil could return land to life after wildfires
READ MORE: Could bacteria help fix the smoky taste of wildfire-tainted wine?
Over a period of five years, Glassman and her team built a collection of fungi gathered from seven different wildfire burn sites across California. The researchers sequenced their genes and exposed some of them to charcoal. They found three main ways through which pyrophilous fungal genes have evolved.
Copy-paste mechanism
Some of the fungi use gene duplication, like a biological copy-paste mechanism, to make more of the enzymes needed to digest charcoal. Aspergillus, the green mold sometimes found on bread, reproduce asexually using this method. The more copies of charcoal-digesting genes it has, the more enzymes it can produce to consume burned matter full of carbon.
By contrast, Basidiomycota, a large group that contains the classic Mario Brothers-style mushroom-forming species, relies on sexual reproduction. This strategy allows it to recombine genes during mating, and quickly evolve the ability to metabolize char.
Most surprising to the researchers, however, is that one fungus, Coniochaeta hoffmannii, acquired its most useful genes from bacteria, essentially borrowing genetic tools from another kingdom of life.
Horizontal gene transfer
Humans share genes via vertical transfer, from parents to babies. Bacteria commonly swap genes with each other horizontally. “Horizontal gene transfer is like you sharing genes with your friend or sibling,” Glassman said. “This is why bacteria are so diverse.” However, it is uncommon to find examples of this happening between bacteria and other life forms.
“This kind of gene sharing across kingdoms is incredibly rare,” Glassman said. “But it gives this fungus the genes it needs to break down burn scars.”
The team also identified how some fungi survive fire itself. Some produce sclerotia, heat-resistant structures that can lie dormant underground for decades, waiting for the right conditions to regrow.
Others survive deeper in the soil, then rise to colonize nutrient-rich, competitor-free ground after the fire passes. For example, Pyronema does not possess as much of the genetic machinery to break down charcoal. Instead, it quickly forms tiny orange cup-shaped mushrooms in a competitor-free environment.
Cleaning up the land
Understanding how certain fungi are able to break down charcoal could ultimately benefit humans. Charcoal is chemically similar to a lot of pollutants left behind by human activities like oil spills, mining waste, and other industrial processes. If researchers gain a better understanding of the ways fungi digest such things, they could one day be used to clean up contaminated environments.
While there are a number of books written about the ways that plants survive fires, there is much less information about fungi.
“There are a lot of ways these genes can be harnessed to clean up oil spills or break down ores or help restore burned landscapes,” Glassman said. “It’s a very new area with potentially a lot of beneficial applications.”
No comments yet